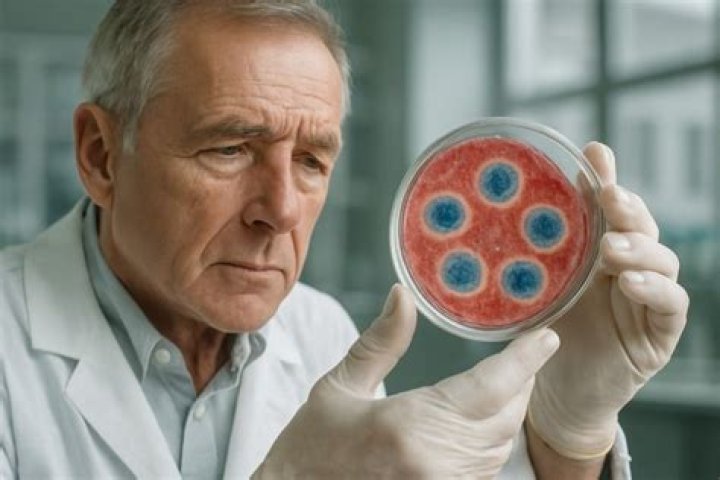

Can I learn Java in 15 Days

Emily Dawson
Published Apr 30, 2026
Indeed, JAVA is one of the most demanding programming languages in the IT world. Additionally, you can learn this particular language efficiently by following a relevant pathway and with genuine hard work & dedication. …
Can I learn Java in 20 Days?
Indeed, JAVA is one of the most demanding programming languages in the IT world. Additionally, you can learn this particular language efficiently by following a relevant pathway and with genuine hard work & dedication. …
How can I learn to code in 15 days?
- Udacity. …
- Lrn. …
- Tynker. …
- Lynda Apps. …
- Swifty. …
- Javvy. …
- Codecademy Hour of Code. …
- CodeCombat.
How many days will it take to learn Java?
On average, becoming a confident Java programmer takes about 1–2 years, considering you spend 2–3 hours per day practicing coding. Familiarising yourself with the language to the point where you can edit someone else’s code or write basic apps can take as little as four months.Can I learn Java in 21 Days?
In just 21 days you can acquire the knowledge and skills necessary to develop applications on your computer and apps that run on Android phones and tablets. … By the time you have finished the book, you’ll have well-rounded knowledge of Java and the Java class libraries.
Can I learn Java one day?
Learning Java in one day is not that easy. You won’t be able to grasp all the concepts. Yes, it would be an advantage if you have learned other programming languages such as C or C++ but learning it in one day is quite difficult. Proficiency takes time and might take a few months as well.
Which is best Python or Java?
DimensionsJavaPythonTypingStatically-typedDynamically-typedVerbosityVerboseConciseCompiled/ InterpretedCompiledInterpreted
How many hours learn Javascript?
2 hours a day are enough to learn Javascript basics, and learning the core basics of JS can take you 5 to 6 weeks, given that you know some of the basics in computer science and some prior experience of algorithms.Is Java easy or hard?
Compared to other programming languages, Java is fairly easy to learn. Of course, it’s not a piece of cake, but you can learn it quickly if you put in the effort. It’s a programming language that is friendly to beginners. Through any java tutorial, you’ll learn how object-oriented it is.
What is the fastest way to learn Java?- Codecademy. Codecademy is probably one of the best places to learn Java online. …
- Udemy. Udemy offers Java tutorials from complete beginner to expert level. …
- Coursera. …
- Java Code Geeks. …
- Learn Java. …
- Oracle Java Tutorials. …
- edX. …
- SoloLearn.
Can I learn coding in 30 days?
Learning how to program is challenging and will take time. But if you use those 30 days to soak up as much as you can and build a daily coding habit, then success is inevitable. If you’re ready to get started but still unsure where to begin, I recommend you check out the Codecademy Web Development course.
How do I learn Java?
- Understand the basics: Learning the basics of any programming language is very important. …
- Patience is the key: …
- Practice Coding. …
- Read about Java regularly. …
- Study in a group.
How do I start coding from zero level?
- Learn the basic concepts of coding first. …
- Choose the right language. …
- Pick a language that demonstrates low-level concepts. …
- Avoid popular languages if possible. …
- Choose a language based on your goals. …
- Learn by hands-on coding, not just reading.
Can I learn Java at home?
Luckily, you can practice Java programming from home without the need for any fancy software or facilities, so the best thing to do is get started once you’ve come to grips with the basics.
Can I learn JavaScript in a week?
You got to practice a lot and side by side keep learning. . If you are focused then may be you can learn the basics in a week. But to be job ready will take you few months and to be reasonably good with all concepts of JavaScript will take you few years.
Can I learn Java One month?
Everyone wants to learn Java programming as soon as possible, but it is not easy. To become a successful Java developer, the only way is to do the practice of all basics and advanced concepts of it. If we follow the following learning path, we can learn Java in one month only.
Is Java enough to get a job?
Java might be enough to get a job. However, most jobs require a set of skills. Specialization is helpful, but technical versatility is also critical. For example, you might get a job to write Java code that connects to a MySQL database.
Is Java good for coding interviews?
There are some languages that are more suitable than others for coding interviews. Then there are some that you absolutely want to avoid. From my experience as an interviewer, most candidates pick Python or Java. … Java is a decent choice too.
Which pays more Java or Python?
According to the 2020 Stack Overflow survey, it’s a very close call when it comes to Python vs Java salary. In the U.S., Python developers make on average $120k a year, and Java developers make the same.
Can I learn Java in 3 months?
Originally Answered: Is it possible to learn Java in 3 months? Yes, Learning java in 3 months is possible. Although, it would require a lot of time to master it but at least in three months you can get good knowledge about Java SE.
Should I learn Python or Java first?
If you’re just interested in programming and want to dip your feet in without going all the way, learn Python for its easier to learn syntax. If you plan to pursue computer science/engineering, I would recommend Java first because it helps you understand the inner workings of programming as well.
Can I learn Java without knowing C++?
Yes, There is no need to have knowledge of C/C++ to learn java. Its a programming language and it has it’s own syntax, different from other. You can learn that from scratch. Actually, there are schools/institutes that teach java for first programming class to the students.
Is Java easier than Python?
Java is generally faster and more efficient than Python because it is a compiled language. As an interpreted language, Python has simpler, more concise syntax than Java. It can perform the same function as Java in fewer lines of code.
Who qualifies for Java course?
- Candidates who have completed class 12th, graduation or post-graduation from a recognised college/ university.
- Candidates should have basic knowledge of computer language.
- Admission to Java certifications is based on the merit list.
Is HTML easier than Java?
In my opinion HTML is the easiest one to learn first and is very useful for web development. Even C++ is easier to learn when compared to java. In java you have to learn about many inbuilt packages which takes more time. But in C++, you can start coding with basic knowledge.
Can I learn JavaScript without HTML and CSS?
Will you need to learn HTML and CSS to learn JavaScript? Yes. … In fact, HTML and CSS are so good and easy for creating GUI, that many other languages are starting to adopt it as their way of creating GUI. So, learning HTML and CSS is not only easy compared to learning GUI in other languages, it is more useful too.
Can I get a job with just JavaScript?
If you definitely do not like front-end work, it is possible to find a job with only JavaScript, but it’s an unusual path. You will likely have an easier time finding a role if you learn a different server-side language like Python or Go as well as JavaScript.
Why is JavaScript so hard?
JavaScript is so hard to learn because it’s an asynchronous programming language. It’s also single-threaded, which means it uses its asynchronous nature in a radically different way than most other programming languages. … Or we could communicate asynchronously.
Which is the best app to learn Java?
- SoloLearn. Programming languages. …
- Programming Hub. …
- CodeGym. …
- Enki. …
- Easy Coder. …
- Encode. …
- Codecademy. …
- Learn Java Programming.
Which is the best course in Java?
- Object-Oriented Programming in Java Specialization by Coursera. …
- The Complete Java Masterclass by Udemy. …
- Java Programming: Solving Problems with Software by Coursera. …
- Java Fundamentals by Pluralsight. …
- Java Programming for Complete Beginners by Udemy. …
- Java In-Depth by Udemy.
What is next step after learning Java?
The next step should always be “find opportunities to apply your new skill”. To learn a skill, to become “proficient”, and later to become “expert”, one needs practice.